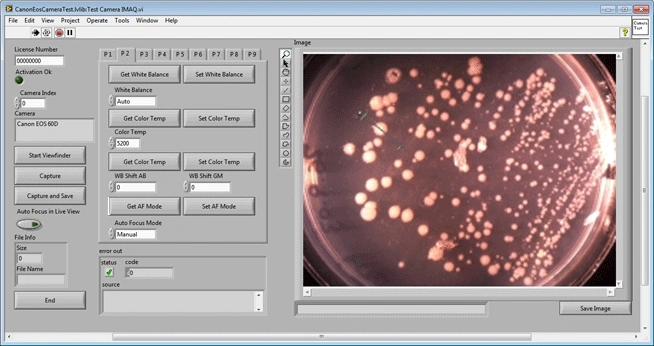
screenshot

-
 Try out the new Jake: AI Coding Assistant for LabVIEW!
Try out the new Jake: AI Coding Assistant for LabVIEW!
Get answers to questions about LabVIEW and discuss your code.
Camera Control For Canon EOS by Ackermann Automation GmbH - Toolkit for LabVIEW Download
| Version | 4.1.0.33 |
| Released | Nov 18, 2020 |
| Publisher | Ackermann Automation GmbH |
| License | Development license from Ackermann Automation |
| LabVIEW Version | LabVIEW>=13.0 |
| Operating System | Windows |
| Project links | Homepage |
Description
The "Camera Control for Canon EOS" is a library for control of Canon EOS cameras via USB. The following functionality is included.
- Image capturing
- Live View
- Movie shooting
- Camera properties access
- File system access
The following cameras are supported:
EOS Kiss M2 / EOS M50 Mark II
EOS R5
EOS R6
EOS Kiss X10i / EOS Rebel T8i / EOS 850D
EOS Ra
EOS-1D X Mark III
EOS M200
EOS M6 Mark II
EOS 90D
PowerShot G7X Mark III
PowerShot G5X Mark II
EOS Kiss X10 / EOS Rebel SL3 / EOS 250D / EOS 200D II
EOS RP
PowerShot SX70 HS
EOS R
EOS Kiss M / EOS M50
EOS Kiss X90 / EOS REBEL T7 / EOS 2000D / EOS 1500D
EOS REBEL T100/EOS 4000D / EOS 3000D
EOS 6D Mark II
EOS Kiss X9 / EOS Rebel SL2 / EOS 200D
EOS Kiss X9i / EOS Rebel T7i / EOS 800D
EOS 9000D / EOS 77D
EOS 5D Mark IV
EOS-1D X Mark II
EOS 80D
EOS Kiss X80 / EOS Rebel T6 / EOS 1300D
EOS 5DS
EOS 5DS R
EOS 8000D / EOS REBEL T6sEOS 760D
EOS Kiss X8i / EOS REBEL T6i / EOS 750D
EOS 7D Mark II
EOS Kiss X70/EOS 1200D/EOS REBEL T5/EOS Hi
EOS 70D
EOS Kiss X7 / EOS 100D / EOS REBEL SL1
EOS Kiss X7i / EOS 700D / EOS REBEL T5i
EOS-1D C
EOS 6D
EOS Kiss X6i / EOS 650D / EOS REBEL T4i
EOS-1D X
EOS 5D Mark III
EOS Kiss X50 / EOS REBEL T3 / EOS 1100D
EOS Kiss X5 / EOS REBEL T3i / EOS 600D
EOS 60D
EOS Kiss X4 / EOS REBEL T2i / EOS 550D
EOS-1D Mark IV
EOS 7D
EOS Kiss X3 / EOS REBEL T1i / EOS 500D
EOS 5D Mark II
EOS 50D
EOS DIGITAL REBEL XS / 1000D/ KISS F
EOS DIGITAL REBEL Xsi / 450D / Kiss X2
EOS-1Ds Mark III
EOS 40D
EOS-1D Mark III
Licensing:
A developement license is needed to use the library. It is protected with a simple mechanism. An activation key has to be entered in the block diagramm of the openSystem.vi. Each company will receive a different activation key.

